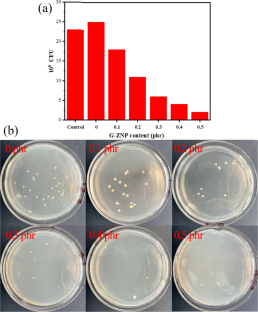

Abstract
Graphene-doped ZnO nanoplates (G-ZNPs) were incorporated as a reinforcing material into polyvinyl alcohol (PVA) to prepare nanocomposite PVA/G-ZNP hydrogels through a cyclic freezing-thawing method. The mechanical properties, water content, gel fraction, swelling ratio, dye absorption, water contact angle, thermal stability, and antibacterial properties were explored. In addition, the nanocomposites were characterized using Fourier transform infrared (FTIR) spectroscopy, X-ray diffraction (XRD), scanning electron microscopy (SEM), and energy-dispersive X-ray spectroscopy (EDS). The tensile strengths of the hydrogels increased from 1.9 to 2.2 MPa when the G-ZNP content ranged from 0 to 0.3 phr. The mechanical properties of the xerogels (obtained from freeze drying the hydrogels for 24 and 48 h) were the same as those of the hydrogels. Increasing the G-ZNP content improved the swelling ratio and dye absorption capacity because of the higher porosity, and the maximum ratio and capacity were reached when the G-ZNP content was 0.4 phr. The contact angle increased with addition of G-ZNP because of the more compact structures of the nanocomposite PVA/G-ZNP hydrogels and the lower surface roughnesses. The results of FTIR analyses showed that PVA underwent coordination reactions and hydrogen bonding with the G-ZNPs, and these synergistically enhanced the tensile strength of the PVA. The results of XRD analyses showed that with an increase in the G-ZNP content, the crystallinity of the xerogels first decreased and then increased. When the G-ZNP content was 0.3 phr, the crystallinity was the lowest, implying that at a content greater than 0.3 phr, the G-ZNP nanomaterials would not be well dispersed. Moreover, EDS analyses showed that the G-ZNPs were relatively uniformly dispersed in PVA hydrogels at a content of 0.3 phr. SEM analyses showed that incorporation of a small amount of G-ZNPs changed the microscopic morphology of the gels, and the three-dimensional network structure of the nanocomposite gels became dense. In addition, G-ZNPs enhanced the antibacterial and dye absorption abilities of the hydrogels.
This is a preview of subscription content, access via your institution
Access options
Subscribe to this journal
Receive 12 print issues and online access
$259.00 per year
only $21.58 per issue
Buy this article
- Purchase on SpringerLink
- Instant access to the full article PDF.
USD 39.95
Prices may be subject to local taxes which are calculated during checkout

Similar content being viewed by others
References
Wang Y, Adokoh CK, Narain R. Recent development and biomedical applications of self-healing hydrogels. Expert Opin Drug Deliv. 2018;15:77–91.
Ebrahimi F, Ramezani Dana H. Poly lactic acid (PLA) polymers: from properties to biomedical applications. Int J Polym Mater Polym Biomater. 2021;13:1–14.
Zaikov GE, Gumargalieva KZ, Polishchuk AY, Adamyan AA, Vinokurova TI. Biodegradation of polyolefins biomedical applications. Polym Plast Technol Eng. 1999;38:621–46.
Wang J, Nor Hidayah Z, Razak SIA, Kadir MRA, Nayan NHM, Li Y, et al. Surface entrapment of chitosan on 3D printed polylactic acid scaffold and its biomimetic growth of hydroxyapatite. Compos Interfaces. 2019;26:465–78.
Qiao Z, Cao M, Michels K, Hoffman L, Ji HF. Design and fabrication of highly stretchable and tough hydrogels. Polym Rev. 2020;60:420–41.
Husain MSB, Gupta A, Alashwal BY, Sharma S. Synthesis of PVA/PVP based hydrogel for biomedical applications: a review. Energy Sources Part A. 2018;40:2388–93.
Idumah CI, Nwuzor I, Odera SR. Recent advancements in self-healing polymeric hydrogels, shape memory, and stretchable materials. Int J Polym Mater Polym Biomater. 2021;70:941–66.
Kumar A, Han SS. PVA-based hydrogels for tissue engineering: a review. Int J Polym Mater Polym Biomater. 2017;66:159–82.
Sood N, Bhardwaj A, Mehta S, Mehta A. Stimuli-responsive hydrogels in drug delivery and tissue engineering. Drug Deliv. 2016;23:748–70.
Samaddar P, Kumar S, Kim KH. Polymer hydrogels and their applications toward sorptive removal of potential aqueous pollutants. Polym Rev. 2019;59:418–64.
Wichterle O, Lim D. Hydrophilic gels for biological use. Nature. 1960;185:117–8.
Ren T, Gan J, Zhou L, Chen H. Physically crosslinked hydrogels based on poly (vinyl alcohol) and fish gelatin for wound dressing application: fabrication and characterization. Polymers. 2020;12:1729.
Moulay S. Poly (vinyl alcohol) functionalizations and applications. Polym Plast Technol Eng. 2015;54:1289–319.
Cheng Y, Hu Y, Xu M, Qin M, Lan W, Huang D, et al. High strength polyvinyl alcohol/polyacrylic acid (PVA/PAA) hydrogel fabricated by Cold-Drawn method for cartilage tissue substitutes. J Biomater Sci Polym Ed. 2020;31:1836–51.
Lan W, Xu M, Zhang X, Zhao L, Huang D, Wei X, et al. Biomimetic polyvinyl alcohol/type II collagen hydrogels for cartilage tissue engineering. J Biomater Sci Polym Ed. 2020;31:1179–98.
Mansur HS, Sadahira CM, Souza AN, Mansur AA. FTIR spectroscopy characterization of poly (vinyl alcohol) hydrogel with different hydrolysis degree and chemically crosslinked with glutaraldehyde. Mater Sci Eng C. 2008;28:539–48.
El Salmawi KM. Gamma radiation-induced crosslinked PVA/chitosan blends for wound dressing. J Macromol Sci Part A. 2007;44:541–5.
Zhang X, Zhang G, Zhang H, Liu X, Shi J, Shi H, et al. A bifunctional hydrogel incorporated with CuS@ MoS2 microspheres for disinfection and improved wound healing. Chem Eng J. 2020;382:122849.
Sinha A, Das G, Sharma BK, Roy RP, Pramanick AK, Nayar S. Poly (vinyl alcohol)–hydroxyapatite biomimetic scaffold for tissue regeneration. Mater Sci Eng: C 2007;27:70–74.
Su C, Su Y, Li Z, Haq MA, Zhou Y, Wang D. In situ synthesis of bilayered gradient poly (vinyl alcohol)/hydroxyapatite composite hydrogel by directional freezing-thawing and electrophoresis method. Mater Sci Eng C Mater Biol Appl. 2017;77:76–83.
Hou R, Zhang G, Du G, Zhan D, Cong Y, Cheng Y, et al. Magnetic nanohydroxyapatite/PVA composite hydrogels for promoted osteoblast adhesion and proliferation. Colloids Surf B. 2013;103:318–25.
Asadi N, Alizadeh E, Salehi R, Khalandi B, Davaran S, Akbarzadeh A. Nanocomposite hydrogels for cartilage tissue engineering: a review. Artif Cells Nanomed Biotechnol. 2018;46:465–71.
Tsou CH, Yao WH, Lu YC, Tsou CY, Wu CS, Chen J, et al. Antibacterial property and cytotoxicity of a poly (lactic acid)/nanosilver-doped multiwall carbon nanotube nanocomposite. Polymers. 2017;9:100.
Zhang L, Wang Z, Xu C, Li Y, Gao J, Wang W, et al. High strength graphene oxide/polyvinyl alcohol composite hydrogels. J Mater Chem. 2011;21:10399–406.
Shadjou N, Hasanzadeh M, Khalilzadeh B. Graphene based scaffolds on bone tissue engineering. Bioengineered. 2018;9:38–47.
Kashyap S, Pratihar SK, Behera SK. Strong and ductile graphene oxide reinforced PVA nanocomposites. J Alloy Compd. 2016;684:254–60.
Thayumanavan N, Tambe P, Joshi G, Shukla M. Effect of sodium alginate modification of graphene (by ‘anion-π’type of interaction) on the mechanical and thermal properties of polyvinyl alcohol (PVA) nanocomposites. Compos Interfaces. 2014;21:487–506.
Kumar S, Krishnakumar B, Sobral AJ, Koh J. Bio-based (chitosan/PVA/ZnO) nanocomposites film: Thermally stable and photoluminescence material for removal of organic dye. Carbohydr Polym. 2019;205:559–64.
Patil PP, Meshram JV, Bohara RA, Nanaware SG, Pawar SH. ZnO nanoparticle-embedded silk fibroin–polyvinyl alcohol composite film: a potential dressing material for infected wounds. N J Chem. 2018;42:14620–9.
Yao YL, De Guzman MR, Duan H, Gao C, Lin X, Wen YH, et al. Infusing high-density polyethylene with graphene-zinc oxide to produce antibacterial nanocomposites with improved properties. Chin J Polym Sci. 2020;38:898–907.
Unar IN, Soomro SA, Aziz S. Effect of various additives on the physical properties of polyvinylchloride resin. Pak J Anal Environ Chem. 2010;11:7.
Tsou CH, Ma ZL, Yang T, De Guzman MR, Chen S, Wu CS, et al. Reinforced distiller’s grains as bio-fillers in environment-friendly poly (ethylene terephthalate) composites. Polym Bull. 2022:1–22. https://doi.org/10.1007/s00289-022-04318-8.
Guo J, Tsou CH, Yu Y, Wu CS, Zhang X, Chen Z, et al. Conductivity and mechanical properties of carbon black-reinforced poly (lactic acid)(PLA/CB) composites. Iran Polym J. 2021;30:1251–62.
Sellam C, Zhai Z, Zahabi H, Picot OT, Deng H, Fu Q, et al. High mechanical reinforcing efficiency of layered poly (vinyl alcohol)–graphene oxide nanocomposites. Nanocomposites. 2015;1:89–95.
Khalilipour A, Paydayesh A. Characterization of polyvinyl alcohol/ZnO nanocomposite hydrogels for wound dressings. J Macromol Sci Part B Phys. 2019;58:371–84.
He Y, Sang W, Wang JA, Wu R, Min J. Polymer-assisted complexing controlled orientation growth of ZnO nanorods. J Nanopart Res. 2005;7:307–11.
Ma ZL, Tsou CH, Cui X, Wu J, Lin L, Wen H, et al. Barrier properties of nanocomposites from high-density polyethylene reinforced with natural attapulgite. Curr Res Green Sustain Chem. 2022;5:100314.
Tsou CH, Chen ZJ, Yuan S, Ma ZL, Wu CS, Yang T, et al. The preparation and performance of poly (butylene adipate) terephthalate/corn stalk composites. Curr Res Green Sustain Chem. 2022;5:100329.
Wen YH, Tsou CH, De Guzman MR, Huang D, Yu YQ, Gao C, et al. Antibacterial nanocomposite films of poly (vinyl alcohol) modified with zinc oxide-doped multiwalled carbon nanotubes as food packaging. Polym Bull. 2022;79:3847–66.
Sirousazar M, Khadivi H, Delir S. Swelling and drying mechanisms of freeze-thawed polyvinyl alcohol/egg white/montmorillonite bionanocomposite hydrogels. J Macromol Sci Part B Phys. 2020;59:309–30.
Tsou CH, Wu CS, Hung WS, De Guzman MR, Gao C, Wang RY, et al. Rendering polypropylene biocomposites antibacterial through modification with oyster shell powder. Polymers. 2019;160:265–71.
Tsou CH, Zhao L, Gao C, Duan H, Lin X, Wen Y, et al. Characterization of network bonding created by intercalated functionalized graphene and polyvinyl alcohol in nanocomposite films for reinforced mechanical properties and barrier performance. Nanotechnology. 2020;31:385703.
Agarwal S, Sadegh H, Monajjemi M, Hamdy AS, Ali GA, Memar AO, et al. Efficient removal of toxic bromothymol blue and methylene blue from wastewater by polyvinyl alcohol. J Mol Liq. 2016;218:191–7.
Umoren SA, Etim UJ, Israel AU. Adsorption of methylene blue from industrial effluent using poly (vinyl alcohol). J Mater Environ Sci. 2013;4:75–86.
Belyaeva LA, Van Deursen PM, Barbetsea KI, Schneider GF. Hydrophilicity of graphene in water through transparency to polar and dispersive interactions. Adv Mater. 2018;30:1703274.
Liu C, Liu H, Xiong T, Xu A, Pan B, Tang K. Graphene oxide reinforced alginate/PVA double network hydrogels for efficient dye removal. Polymers. 2018;10:835.
Wan Z, Chen D, Pei H, Liu J, Liang S, Wang X, et al. Batch study for Pb2+ removal by polyvinyl alcohol–biochar macroporous hydrogel bead. Environ Technol. 2021;42:648–58.
Tsou CH, Ma ZL, De Guzman MR, Zhao L, Du J, Emori W, et al. High-performance antibacterial nanocomposite films with a 3D network structure prepared from carboxylated graphene and modified polyvinyl alcohol. Prog Org Coat. 2022;166:106805.
Ma ZL, Tsou CH, Yao YL, De Guzman MR, Wu CS, Gao C, et al. Thermal properties and barrier performance of antibacterial high-density polyethylene reinforced with carboxyl graphene-grafted modified high-density polyethylene. Ind Eng Chem. 2021;60:12911–22.
Ge FF, Wan N, Tsou CH, Chen JC, Wu CS, De Guzman MR, et al. Thermal properties and hydrophilicity of antibacterial poly (phenylene sulfide) nanocomposites reinforced with zinc oxide-doped multiwall carbon nanotubes. J Polym Res. 2022;29:1–19.
Khan MUA, Yaqoob Z, Ansari MNM, Razak SIA, Raza MA, Sajjad A, et al. Chitosan/poly vinyl alcohol/graphene oxide based pH-responsive composite hydrogel films: drug release, anti-microbial and cell viability studies. Polymers. 2021;13:3124.
Dave HK, Nath K. Graphene oxide incorporated novel polyvinyl alcohol composite membrane for pervaporative recovery of acetic acid from vinegar wastewater. J Water Process Eng. 2016;14:124–34.
Wenzel RN. Surface roughness and contact angle. J Phys Chem. 1949;53:1466–7.
Nurly H, Yan Q, Song B, Shi Y. Effect of carbon nanotubes reinforcement on the polyvinyl alcohol–polyethylene glycol double-network hydrogel composites: a general approach to shape memory and printability. Eur Polym. 2019;110:114–22.
Fang H, Wang J, Li L, Xu L, Wu Y, Wang Y, et al. A novel high-strength poly (ionic liquid)/PVA hydrogel dressing for antibacterial applications. Chem Eng J. 2019;365:153–64.
Bai J, Li Y, Yang S, Du J, Wang S, Zheng J, et al. A simple and effective route for the preparation of poly (vinylalcohol)(PVA) nanofibers containing gold nanoparticles by electrospinning method. Solid State Commun. 2007;141:292–5.
Khanna PK, Singh N, Charan S, Subbarao VVVS, Gokhale R, Mulik UP. Synthesis and characterization of Ag/PVA nanocomposite by chemical reduction method. Mater Chem Phys. 2005;93:117–21.
Da Cunha MCPM, Weber M, Nart FC. On the adsorption and reduction of NO3− ions at Au and Pt electrodes studied by in situ FTIR spectroscopy. J Electroanal Chem. 1996;414:163–70.
Reddy MO, Chandra Babu B. Structural, optical, electrical, and magnetic properties of PVA: Gd3. Eng Mater Sci. 2015;2015:1–8.
Osipov AA, Osipova LM, Hruška B, Osipov AA, Liška M. FTIR and Raman spectroscopy studies of ZnO-doped BaO⋅ 2B2O3 glass matrix. Vib Spectrosc. 2019;103:102921.
Mbhele ZH, Salemane MG, Van Sittert CGCE, Nedeljković JM, Djoković V, Luyt AS. Fabrication and characterization of silver− polyvinyl alcohol nanocomposites. Chem Mater. 2003;15:5019–24.
Guo R, Ma X, Hu C, Jiang Z. Novel PVA–silica nanocomposite membrane for pervaporative dehydration of ethylene glycol aqueous solution. Polymers. 2007;48:2939–45.
Bonilla J, Fortunati ELENA, Atarés L, Chiralt A, Kenny JM. Physical, structural and antimicrobial properties of poly vinyl alcohol–chitosan biodegradable films. Food Hydrocoll. 2014;35:463–70.
Ma XD, Qian XF, Yin J, Xi HA, Zhu ZK. Preparation and characterization of polyvinyl alcohol-capped CdSe nanoparticles at room temperature. J Colloid Interface Sci. 2002;252:77–81.
Nouh SA, Bahareth RA. Effect of electron beam irradiation on the structural, thermal and optical properties of poly (vinyl alcohol) thin film. Radiat Eff Defects Solids. 2013;168:274–85.
Ranade A, Nayak K, Fairbrother D, D’Souza NA. Maleated and non-maleated polyethylene–montmorillonite layered silicate blown films: creep, dispersion and crystallinity. Polymers. 2005;46:7323–33.
Yang CC, Lee YJ, Yang JM. Direct methanol fuel cell (DMFC) based on PVA/MMT composite polymer membranes. J Power Sources. 2009;188:30–37.
Liu D, Sun X, Tian H, Maiti S, Ma Z. Effects of cellulose nanofibrils on the structure and properties on PVA nanocomposites. Cellulose. 2013;20:2981–9.
Singh AK, Viswanath V, Janu VC. Synthesis, effect of capping agents, structural, optical and photoluminescence properties of ZnO nanoparticles. J Lumin. 2009;129:874–8.
Tsou CH, Chen S, Li X, Chen JC, De Guzman MR, Sun YL, et al., Highly resilient antibacterial composite polyvinyl alcohol hydrogels reinforced with CNT-NZnO by forming a network of hydrogen and coordination bonding. J Polym Res. 2022. https://doi.org/10.1007/s10965-022-03248-3.
Acknowledgements
The authors would like to acknowledge financial support from the following organizations: Sichuan Province Science and Technology Support Program (2022JDTD0016); Chengdu Science and Technology (2021-RC02-00005-CG); Zigong City Science and Technology (2019CXRC01; 2020YGJC13); Opening Project of Material Corrosion and Protection Key Laboratory of Sichuan Province (2019CL05; 2020CL19); Opening Project of Sichuan Province, the Foundation of Introduced Talent of Sichuan University of Science and Engineering (2017RCL16; 2019RC05); the Opening Project of Key Laboratories of Fine Chemicals and Surfactants in Sichuan Provincial Universities (2020JXY04); Xi’an Weijingyi Art and Culture Communication Co., Ltd (HX2021385).
Author information
Authors and Affiliations
Corresponding author
Ethics declarations
Conflict of interest
The authors declare no competing interests.
Additional information
Publisher’s note Springer Nature remains neutral with regard to jurisdictional claims in published maps and institutional affiliations.
Supplementary information
Rights and permissions
Springer Nature or its licensor holds exclusive rights to this article under a publishing agreement with the author(s) or other rightsholder(s); author self-archiving of the accepted manuscript version of this article is solely governed by the terms of such publishing agreement and applicable law.
About this article
Cite this article
Chen, S., De Guzman, M.R., Tsou, CH. et al. Hydrophilic and absorption properties of reversible nanocomposite polyvinyl alcohol hydrogels reinforced with graphene-doped zinc oxide nanoplates for enhanced antibacterial activity. Polym J 55, 45–61 (2023). https://doi.org/10.1038/s41428-022-00711-2
Received:
Revised:
Accepted:
Published:
Version of record:
Issue date:
DOI: https://doi.org/10.1038/s41428-022-00711-2
This article is cited by
-
Enhanced Barrier and Antimicrobial Properties of Maleic Anhydride-Modified Polyvinyl Alcohol Nanocomposite Films Embedded with Multiwall Carbon Nanotubes Decorated with Nano ZnO for Food Packaging Applications
Food and Bioprocess Technology (2025)
-
Application of ZnO/rGO/paint composite green environmental decorative materials in indoor living environment for the elderly
Chemical Papers (2025)
-
Antimicrobial activity and nanoremediation of heavy metals using biosynthesized CS/GO/ZnO nanocomposite by Bacillus subtilis ATCC 6633 alone or immobilized in a macroporous cryogel
Microbial Cell Factories (2024)
-
Thermal and barrier properties of nanocomposites prepared from poly(butylene succinate) reinforced with ZnO-decorated graphene
Journal of Polymer Research (2023)
-
Enhancement of tensile, thermal and barrier properties of polyphenylene sulfide/carboxylated graphene antibacterial nanocomposites
Journal of Polymer Research (2023)


